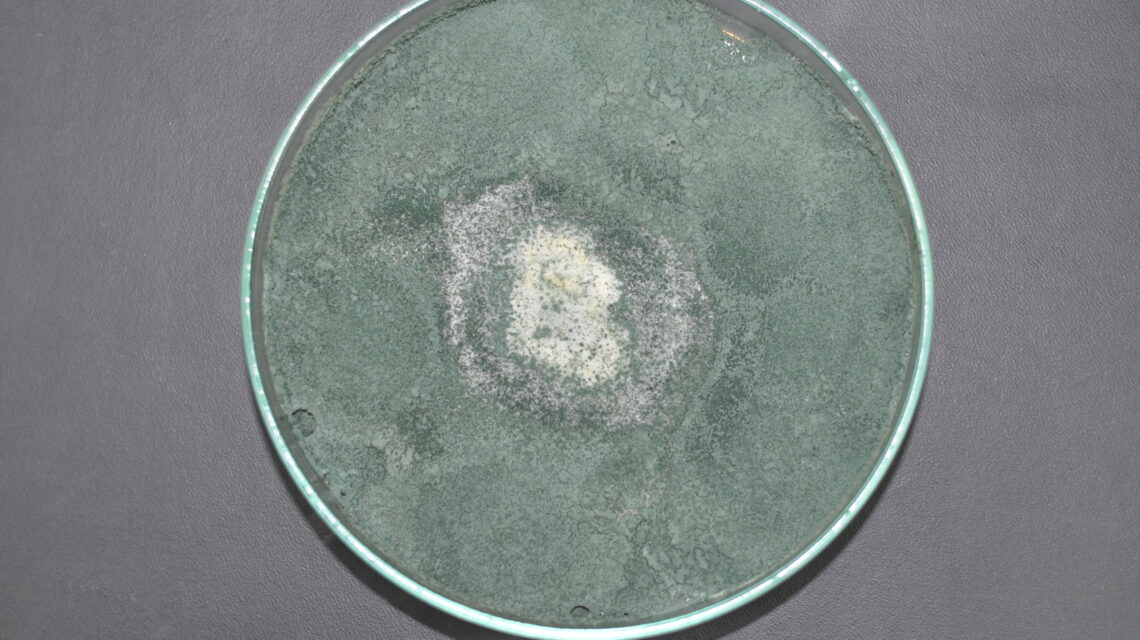

Pemanfaatan entomopatogen dapat menjadi pilihan praktisi perkebunan kelapa sawit dalam upaya pengendalian hama kelapa sawit yang ramah lingkungan. Entomopatogen sendiri sesuai dengan…

Pengendalian hama terpadu (PHT) merupakan prinsip operasional menjaga populasi serangga hama agar tidak melewati ambang batas ekononomi, cara atau upaya pengendalian hama…

Salah satu faktor yang mempengaruhi produktivitas tanaman kelapa sawit adalah ketersediaan bunga jantan dan bunga betina kelapa sawit, atau yang secara umum…
Gangguan pada tanaman kelapa sawit tidak hanya berasal dari serangan hama seperti ulat api, tikus, Oryctes, dan sebagainya, namun dapat juga berasal…

Tanaman kelapa sawit ditinjau dari kebutuhan airnya dapat tumbuh dengan baik pada lahan dengan curah hujan yang cukup, yaitu minimum 1.200 mm/tahun…

Salah satu aktifitas penting dan tidak dapat terlepas dari pengelolaan perkebunan kelapa sawit adalah kegiatan pemupukan, Hal ini menjadi penting karena tanaman…

Kelapa sawit merupakan tanaman penghasil minyak nabati crude palm oil (CPO). Crude palm oil diperoleh dari proses pengolahan tandah buah segar yang…

Kondisi perubahan iklim terjadi pada dua dekade terakhir hampir diseluruh belahan dunia, begitu juga yang terjadi Indonesia, salah satu sektor yang cukup…

Minyak sawit mentah atau crude palm oil (CPO) adalah hasil turunan utama dari kegiatan industri perkebunan kelapa sawit. CPO diperoleh dari kegiatan…

Industri kelapa sawit menjadi salah satu sektor yang berperan penting dalam perekonomian Indonesia. Pengembangan industri kelapa sawit semakin pesat dalam dua dekade…



